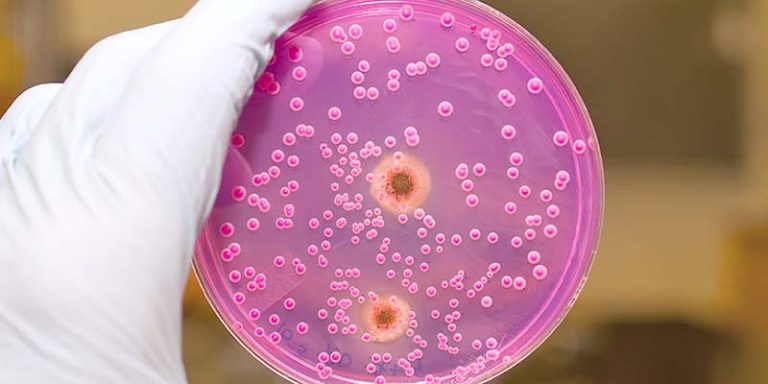

Investigación
Áreas verticales
Neurociencias
El Área de Neurociencias del IIS Biogipuzkoa integra toda la actividad traslacional (investigación clínica, básica y ensayos clínicos) del Servicio de Neurología del Hospital Univesitario Donostia (HUD) y entidades consorciadas.
Está integrada por diferentes Grupos que abordan la patología neuromuscular, la neurodegenerativa del SNC y SNP, la mitocondrial, la neuroinflamatoria, la neurosensorial y las terapias basadas en RNA para todas estas enfermedades y el glioblastoma. Colabora activamente con el Área de Bioingenieria en el campo de la regeneración tisular de músculo y con el Área de Oncología en la línea transversal de envejecimiento, así como con las Plataformas de Cultivos Celulares, Genómica y Biología Computacional.
Cuenta con 2 grupos CIBER integrados en CIBERNED (Instituto de Salud Carlos III) y ha sido la base para la creación de 2 start-up: MIRAMOON Pharma, dedicada al desarrollo de compuestos para enfermedades raras y MIAKER DEVELOPMENT como plataforma de desarrollo preclínico de compuestos en modelos de Drosophila. Por otro lado, integra más de 80 personas (75% mujeres y 27% personal doctor, de 6 nacionalidades diferentes) entre personal clínico, neuropsicólogo, biólogo, farmacéutico, bioquímico, biotecnólogo y técnico de laboratorio, pertenecientes al Instituto, al HUD o a la Universidad del País Vasco/Euskal Herriko Unibertsitatea (EHU).

Responsable de área
 |
Dr. Adolfo López de Munáin |
Saber más
El Dr. Adolfo López de Munain, Jefe del Servicio de Neurología del Hospital Universitario Donostia (OSI Donostialdea) y Coordinador del Área de Neurociencias es, asimismo, Corresponsable del Grupo de Enfermedades Neuromusculares del IIS Biogipuzkoa, donde además de en la línea principal en Enfermedades Neuromusculares, ha participado activamente en el diseño y puesta en marcha de otras líneas de investigación clínica y molecular en Enfermedades Neurodegenerativas. Es autor o coautor de más de 320 artículos revisados, 40 capítulos de libros y monografías y más de 400 comunicaciones en congresos nacionales e internacionales y ponencias invitadas. En este periodo, ha sido director de 20 Tesis Doctorales en algunas de las líneas expuestas. Investigador Principal o colaborador en más de 41 proyectos de I+D+i financiados en convocatorias competitivas de Administraciones o entidades públicas y privadas. Al mismo tiempo, dispone de 6 patentes registradas. Por otro lado, es Director Científico de CIBERned (Centro de Investigación Biomédica en Red de Enfermedades Neurodegenerativas) integrado desde 2022 en CIBER, donde pertenece al programa 3 de investigación sobre Enfermedades Neuromusculares. Además de su trayectoria como neurólogo e investigador biomédico, el Dr. López de Munain es Profesor Asociado de Neurología en la Universidad del País Vasco/Euskal Herriko Unibertsitatea (EHU), miembro del consejo de Salud de Tecnalia y cofundador de 2 start-ups (2019).
Grupos de investigación
Enfermedades Hepáticas y Gastrointestinales
El Área de Enfermedades Hepáticas y Gastrointestinales se centra en la investigación de cánceres gastrointestinales, especialmente el colorrectal, el de páncreas, colangiocarcinoma, hepatocarcinoma y cáncer gástrico.
La investigación aborda prevención, diagnóstico precoz, causas genéticas y tratamiento de estas patologías. También se investiga la patología por Helicobacter pylori, la enfermedad inflamatoria intestinal y las hepatopatías crónicas.
Destaca el desarrollo de una técnica no invasiva para diagnosticar hemocromatosis mediante resonancia magnética, así como estudios sobre predisposición genética y la microbiota intestinal en enfermedades gastrointestinales.

Responsable de área
 | Dr. Luis Bujanda Fernández de Piérola |
Saber más
El Dr. Luis Bujanda Fernández de Piérola es Licenciado en Medicina y Cirugía por la Universidad de Navarra y Especialista en Aparato Digestivo. Catedrático de Medicina en la Universidad del País Vasco/Euskal Herriko Unibertsitatea (EHU) desde el 2019. Jefe de Servicio de Aparato Digestivo en el Hospital Universitario Donostia (OSI Donostialdea) en el periodo 2011-2017. El Dr. Bujanda es el Responsable del Área de Enfermedades Hepáticas y Gastrointestinales del IIS Biogipuzkoa y a su vez del Grupo de Investigación en Enfermedades Gastrointestinales desde 2008. Al mismo tiempo es Jefe de Grupo de Investigación del CIBERehd (Centro de Investigación Biomédica en Red de Enfermedades Hepáticas y Digestivas) desde 2008, Presidente de la Asociación Española de Gastroenterología (2016-2020) y Expresidente de la Fundación Española de Gastroenterología (2021-2022). El Dr. Bujanda cuenta actualmente con 521 publicaciones en PubMed-Medline, un índice de H de 71 (Fuente. Datos Web of ScienceTM), con 19.671 citaciones. Ha dirigido 23 Tesis Doctorales, dos de ellas de carácter internacional. Además de su carrera investigadora, el Dr. Bujanda, en su labor asistencial, atiende a un gran número de pacientes en consultas digestivas (en torno a 40.000 hasta 2021), realizando técnicas endoscópicas y ecográficas que complementan su perfil traslacional.
Grupos de investigación
Enfermedades Infecciosas
Formando parte del Instituto Biogipuzkoa desde su origen, esta Área lidera el estudio de la patología infecciosa, desde la epidemiologia de las enfermedades transmisibles a los ensayos clínicos con nuevos agentes antimicrobianos, pasando por patologías infecciosas tan relevantes como la endocarditis infecciosa, las enfermedades de trasmisión sexual o la resistencia antimicrobiana.
También focaliza su interés en los cambios recientes que se han producido en las enfermedades infecciosas, como la pandemia del SARS-CoV-2, la cronificación del VIH, la irrupción de virus emergentes y la aplicación de nuevas técnicas moleculares al estudio de mundo microbiano (metagenómica, WGS).
Responsable de área
 | Dr. Jose María Marimón Ortiz de Zárate |
Saber más
El Dr. José María Marimón Ortiz De Zárate es Licenciado en Farmacia por la Universidad de Santiago de Compostela (1989) y Doctor en Microbiología por la Universidad del País Vasco/Euskal Herriko Unibertsitatea (EHU) (2000). Especialista en Microbiología y Parasitología Clínica vía FIR (1992-1995). Desde 1997 Facultativo Adjunto del Servicio de Microbiología del Hospital Universitario Donostia (OSI Donostialdea). Jefe de Sección de Biología Molecular y Automatización desde 2013.rnAutor de 95 Publicaciones en revistas indexadas (90 en revistas internacionales y 5 en nacionales), 1 capítulo de libro y 3 Tesis Doctorales dirigidas. Más de 20 proyectos nacionales e internacionales competitivos concedidos, una patente internacional y una prueba diagnóstica comercializada.rnDesde 2011, es docente del Máster del Departamento de Medicina Preventiva y Salud Pública de la Facultad de Medicina de la UPV/EHU. Colaborador del grupo 26 del CIBERes (Centro de Investigación Biomédica en Red de Enfermedades Respiratorias) desde junio de 2006 y Jefe del mismo durante 2017 y 2018. Vocal de la Junta Directiva de la SEIMC entre 2012 y 2015.rnEl Dr. Marimón es Responsable del Área de Enfermedades Infecciosas desde 2024 y a su vez del Grupo de Epidemiologia Infecciosa y Resistencia Antimicrobiana del IIS Biogipuzkoa desde 2017.
Grupos de investigación
Salud Pública, Epidemiología, Atención Primaria e Integral
El Área de Salud Pública, Epidemiología y Atención Primaria e Integral del Instituto estructura su actividad en torno a tres grandes ámbitos de conocimiento:
- Salud Global (One Health)
- atención a la salud y la enfermedad a lo largo de toda la vida
- salud de la mujer
Su actividad investigadora se orienta a comprender y evaluar el impacto de los determinantes ambientales, urbanos y sociales en el estado de salud de la población, así como en el desarrollo de enfermedades agudas y crónicas, con especial atención a los grupos más vulnerables. Asimismo, promueve la salud desde una perspectiva longitudinal, abarcando todas las etapas de la vida —desde el embarazo y la infancia hasta la vejez— e integrando intervenciones desde la salud pública, el ámbito comunitario y la atención primaria.
El Área impulsa la mejora de la atención pediátrica hospitalaria, con especial foco en prematuros y enfermedades raras, y avanza en el conocimiento y abordaje de procesos específicos de la salud de la mujer, como el embarazo, el parto, la menopausia, las enfermedades crónicas y los cánceres ginecológicos. De forma transversal, se trabaja en la optimización del manejo de la cronicidad, la multimorbilidad y la atención integral e integrada, especialmente en personas mayores.
Además, incorpora de manera sistemática la perspectiva del cambio climático, considerando su interacción con las exposiciones ambientales y los estilos de vida, así como su impacto en las estrategias de prevención, promoción de la salud y práctica clínica.
El Área está compuesta por cinco grupos de investigación cuyo enfoque colaborativo y transversal permite afrontar retos clave, como la traslación efectiva del conocimiento a la práctica, la incorporación y desarrollo de nuevo talento investigador —especialmente vinculado al ámbito asistencial y de la salud pública— y el impulso de la participación en iniciativas de ciencia ciudadana.

Responsable de área
 | Dra. Itziar Vergara Micheltorena |
Saber más
La Dra. Itziar Vergara Micheltorena, es Licenciada en Medicina, especialista en Medicina Familiar y Comunitaria, Máster en Salud Pública por la Universidad de California, Berkeley y Doctora en Medicina por la Universidad del País Vasco/Euskal Herriko Unibertsitatea (EHU). Entre 2011 y 2023, ha sido la Responsable de la Unidad de Investigación Atención Primaria y OSIs de Gipuzkoa. Es miembro de la Red Española de Investigación en Servicios y Cronicidad REDISSEC. Asimismo, es Responsable del Área de Salud Pública, Epidemiología, Atención Primaria e Integral y Responsable del Grupo de investigación en Atención Primaria del IIS Biogipuzkoa, donde además lidera la línea de investigación en fragilidad de la Estrategia de Investigación en Envejecimiento . Está dirigiendo dos Tesis Doctorales. Es Investigadora Principal de diversos proyectos de ámbito autonómico, estatal e internacional así como autora de 60 artículos y coinventora de dos patentes relacionados con la promoción del envejecimiento saludable y el abordaje de la fragilidad en atención primaria.
Grupos de investigación
Bioingeniería
La Bioingeniería es la aplicación de los principios y técnicas de la ingeniería al campo de la medicina. Se dedica fundamentalmente al diseño y construcción de productos sanitarios y tecnologías sanitarias tales como equipos médicos, prótesis, dispositivos médicos, dispositivos de diagnóstico y de terapia.
También interviene en la gestión o administración de los recursos técnicos ligados a un sistema de hospitales. Combina la experiencia de la ingeniería con necesidades médicas para obtener beneficios en el cuidado de la salud.
La Bioingeniería es ampliamente reconocida como un campo multidisciplinar, resultado de un largo espectro de disciplinas que la influencian desde diversos campos y fuentes de información. En sus inicios, esta disciplina estuvo ligada fundamentalmente a la aplicación de técnicas de ingeniería eléctrica y electrónica para la construcción de equipos médicos (instrumentación médica), así como al diseño de prótesis y ortesis (biomecánica y rehabilitación). Posteriormente, una parte muy importante de las aplicaciones de la ingeniería a la medicina fue la instrumentación para la adquisición de imágenes del cuerpo humano (imagenología médica).
A partir del desarrollo de los ordenadores, la importancia de la instrumentación fue disminuyendo, mientras que el procesamiento de las señales adquiridas cobró mayor ímpetu debido a que fue posible obtener información adicional a partir de las señales que la instrumentación proporcionaba, y que no era visible directamente a partir de los trazos puros (procesamiento de señales biomédicas).
En la actualidad la disciplina está ligada también a otras como la genómica y proteómica (biología computacional).

Responsable de área
 | Dra. Amaia Cipitria Sagardia |
Saber más
La Dra. Amaia Cipitria es Ikerbasque Research Professor con formación en Bioingeniería y Ciencia de Materiales. Obtuvo su doctorado en Ciencia de Materiales y Metalurgia en la Universidad de Cambridge, Reino Unido, en 2008. Fue investigadora postdoctoral en la Universidad Tecnológica de Queensland, Australia, y en el Hospital Universitario Charité de Berlín, Alemania. Como investigadora principal en la Charité, investigó el efecto de las propiedades físicas de los biomateriales en la respuesta celular y la regeneración ósea in vivo, utilizando técnicas avanzadas de caracterización de materiales. En 2017, recibió una beca Emmy Noether para líder de grupo de investigación independiente de la Fundación Alemana de Investigación y se trasladó al Instituto Max Planck de Coloides e Interfaces (MPI-CI) como líder del grupo de investigación independiente «Matriz extracelular en enfermedades y regeneración». En 2021 regresó a España como Ikerbasque Research Associate en el Instituto de Investigación Sanitaria Biogipuzkoa para iniciar el nuevo grupo de investigación “Bioingeniería en Regeneración y Cáncer”. En 2023, recibió una beca ERC Consolidator Grant (DORMATRIX, 101123883), comenzando en otoño de 2024. Como ex responsable de igualdad de género en el MPI-CI, está comprometida con la promoción de las mujeres en la ciencia. También se desempeña como editora asociada de la revista «Biomaterials Advances».
Grupos de investigación
Oncología
El Área de Investigación de Oncología se dedica a promover la investigación del cáncer mediante el desarrollo de un programa integral de investigación biomédica traslacional.
El objetivo del programa de investigación del Área es, en todo momento, el impacto de los resultados de la investigación sobre los y las pacientes. Para ello se entiende el programa como compartido entre investigadores clínicos y preclínicos y se estructura alrededor de una serie de herramientas estratégicas de impacto y de unas áreas preferentes de interés.
Herramientas estratégicas:
- Biomarcadores predictivos de respuesta a tratamientos sistémicos: inmunoterapia, terapia celular, tratamiento endocrino, tratamientos dirigidos.
- Descripción de nuevas dianas terapéuticas.
- Co-desarrollo de nuevas moléculas terapéuticas en colaboración con iniciativa privada.
- Ensayos clínicos.
- Bases biológicas de la respuesta inmune y taxonomía funcional asociada.
- El estroma tumoral como herramienta taxonómica y diana terapéutica.
Áreas preferentes de interés:
- Tumores con necesidad de taxonomía funcional y modulación de la respuesta inmune: cáncer de pulmón, cáncer de mama, metástasis cerebrales, tumores pleurales.
- Tumores huérfanos de desarrollos específicos dirigidos: tumores del sistema nervioso central, cáncer de mama en el varón, cáncer gástrico, carcinoma escamoso de cabeza y cuello.
- Terapias avanzadas y terapia celular en tumores hematológicos.
- Innovación en programas asistenciales: ejercicio físico, nutrición, circuitos asistenciales.
- Co-desarrollos de tratamiento sistémico y nuevas herramientas de radioterapia.
Los seis grupos en que se subdivide el área, desde sus abordajes específicos, priorizan los programas transversales con herramientas y recursos compartidos.

Responsable de área
 | Dr. Ander Urruticoechea |
Saber más
El Dr. Ander Urruticoechea es Doctor en medicina por la universidad de Barcelona, especialista en Oncología médica. Realizó un periodo de formación doctoral en el Royal Marsden Hospital/Institute for Cancer Research en Londres (2002). En 2004 se incorporó al Institut Català d’Oncologia como responsable de investigación en cáncer de mama, donde además desempeñó labores de director del programa de cáncer de mama (2010-2013). Ha sido Director Científico y Gerente de la Fundación Onkologikoa donde ha compatibilizado su labor asistencial con la investigación domo IP dentro del Grupo de Investigación en Cáncer de mama de Biogipuzkoa y con la responsabilidad de gestión administrativa del centro sanitario (2013-2025). Desde 2025 colabora con la dirección asistencial de la OSI Donostialdea en la mejora de la unión de procesos asistenciales y de investigación clínica y es también co-responsable del Grupo de Investigación en Cáncer de Mama de Biogipuzkoa. Es investigador principal de múltiples ensayos clínicos y de proyectos que se centran en el desarrollo terapéutico en cáncer y la biología molecular del cáncer de mama, así como de varios estudios en innovación asistencial en cáncer. Es autor de numerosas publicaciones en revistas internacionales sobre esta patología. En el ámbito docente ha liderado el grupo de trabajo de generación del Grado en Medicina de la Universidad de Deusto, que vio la luz en 2020, donde actualmente es profesor asociado y coordinador docente de la asignatura Inmunología-Hematología- Oncología. El Dr Urruticoechea es actualmente Presidente del Grupo Español de Cáncer de mama (GEICAM) y miembro de la Junta Directiva del Breast International Group (BIG) (2017). Es también miembro de la Junta Directiva Provincial de la Asociación Contra el Cáncer en Gipuzkoa y Patrono de su Fundación desde las que desarrolla un extenso trabajo de acercamiento de la ciencia a la sociedad y de promoción de proyectos de investigación.

